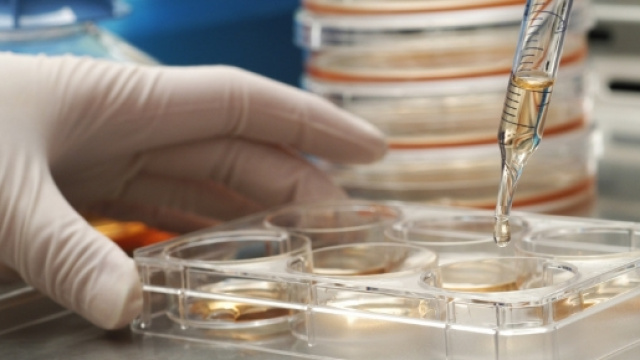
Sclerosi multipla: una nuova terapia basata su cellule staminali ... - cellulestaminalicordoneombelicale.it

Da diverso tempo i medici nutrizionisti consigliano di seguire costantemente un regime basato su prodotti tipici di una dieta mediterranea. Spesso si è sentito parlare di stile alimentare fondato su un 'cesto'di alimenti come ortaggi, frutta di stagione ed il pesce, ancora meglio se si sceglie di acquistare quello ‘azzurro’: la sardina, l'aringa, l'alice, o l'acciuga, lo sgombro, il lanzardo, la costardella ed il pesce spatola ad esempio.
Al pesce va alternatala carne, preferibilmente quella bianca, come pollo, tacchino, coniglio, maiale e vitello; questi cibi sono più salutari e poveri di grassi.
E’ di pubblico dominio la notizia che la dieta mediterraneadiminuisca l’insorgere di cardiopatie ischemiche. E’ nota la sua funzione di 'calmierare' e di diminuire eventuali problematiche cardiovascolari, che producono ipertensione, aumento del peso corporeo, ed alti tassi nel sangue di colesterolo e di glicemia.
In questi giorni è in corso a Monaco di Baviera ilconvegno dell'“European association for the study of diabetes”, dove sono statirivelati i risultati di una nuova ricerca scientifica eseguitadalla Seconda Università degli Studi di Napoli. Quest'ultimo studio spiega un funzionamento dell’organismo umano, finora sconosciuto dal mondo scientifico. Lo stile alimentare mediterraneo dovrebbe preservare e riparare i vasi degli individui affetti da diabete del tipo 2.
Questo tipo di regime nutrizionale è in grado di ‘ricostruire’, lì dove siano danneggiati, i vasi sanguigni. Il nostro organismo attiverebbe un gruppo di cellule, che vanno a pulire e a riparare la patologia diabetica in corso.
La dieta mediterranea potenzierebbe i flussi di circolazione di alcune cellule (distinte e chiamate dagli scienziati ‘endoteliali’) che svolgono la funzione di ricostruire e sostituire i tessuti dei vasi compromessi. L’esito dello studio dell’ateneo partenopeo, esposto a Monaco di Baviera, si è basato su unaricerca svolta su un campione di 215 individui, affetti da diabete di tipo 2. I partecipanti all’ esperimento sono stati raggruppati in due categorie. Il primo gruppo ha seguito un regime alimentare mediterraneo, mentre il secondo una dieta ipocalorica e priva di grassi.
A monte di questostudio sperimentale, gli scienziati hanno misurato conesame clinico emocromocitometrico, i livelli di circolazione delle cellule ‘endoteliali’ dei soggetti esaminati, (ovvero le cellule staminali, la cui origine risiedenel midollo osseo), ed in seguito gli stessi dati sono stati confrontati dopo un anno al termine della dieta mediterranea. A valle di questa innovativa ricerca, i partecipanti che avevano rispettato il regime alimentare mediterraneo, avevanouna quantità maggiore di cellule ‘endoteliali’, in confronto al secondo gruppo appartenente alladieta ipocalorica.
Maria Ida Maiorino, una tra le studiose e promotrici del progetto di questa ricerca, spiega l’esito di questo studio scientifico in una recente intervista: "La nostra analisi clinica costituisce una svolta: gli individui che ‘abbracciano’ una dieta di tipo mediterraneo, con un lieve limite di assunzione di carboidrati, ma abbondante di acidi grassi monoinsaturi, sviluppanonel sangue un considerevole aumento delle cellule endoteliali (staminali), dedite alla ricostruzione e sostituzione delle parti danneggiate dei vasi sanguigni, qualora siano stati compromessi da danni cardiovascolari”.